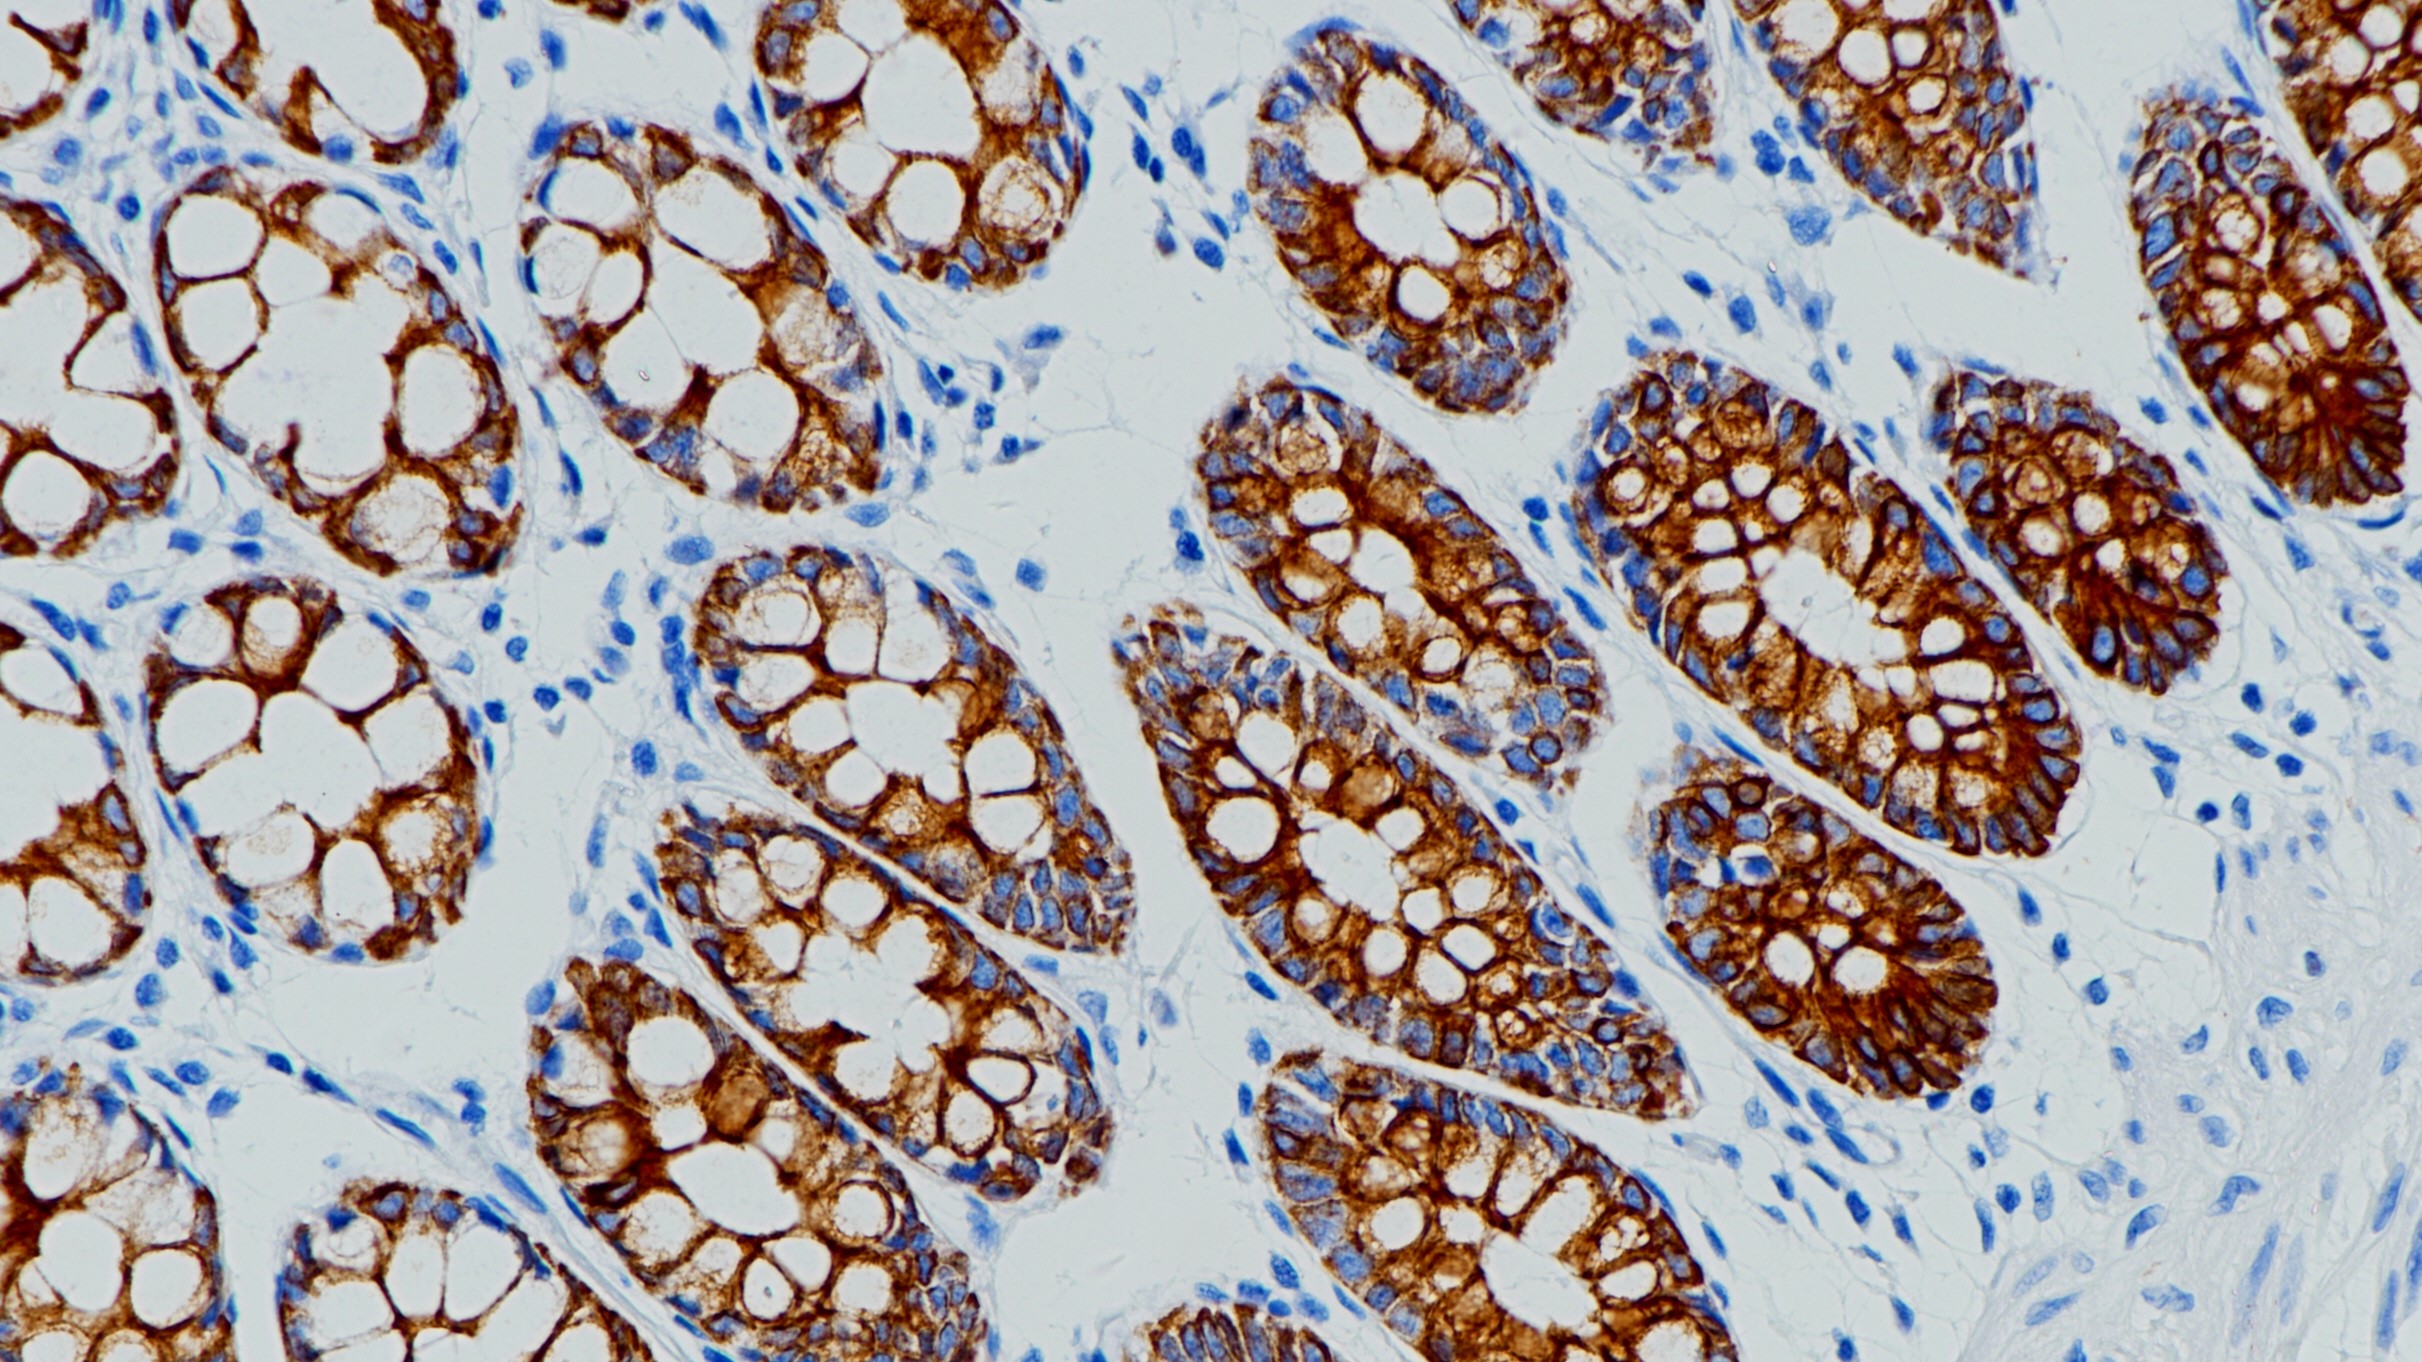
结肠CK18(BP6054)染色

1.Young GD, et al. Differential expression and biodistribution of cytokeratin 18 and desmoplakins in non-small cell lung carcinoma subtypes. Lung Cancer. 2002 May;36 (2):133-41.
2.Woelfle U, et al. Down-regulated expression of cytokeratin 18 promotes progression of human breast cancer. Clin Cancer Res. 2004 Apr 15;10(8):2670-4.
3.中华医学会.《临床技术操作规范·病理学分册》.人民军医出版社,2004.